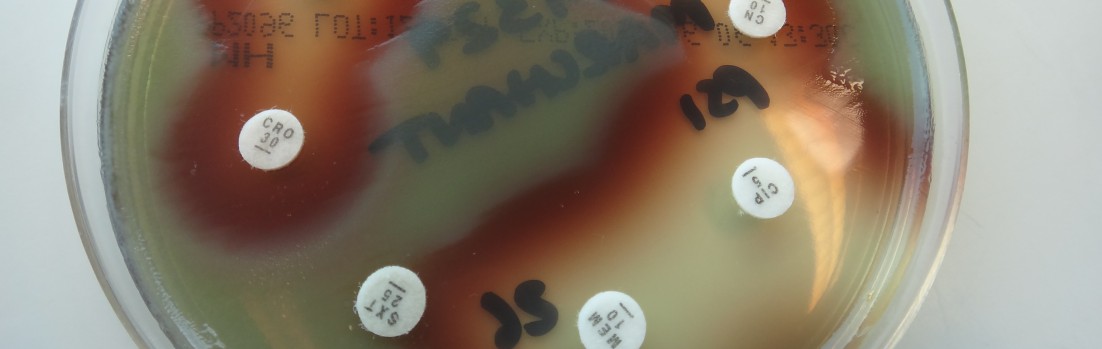

Join 550 other subscribers
Category Cloud
Abdomen/GIT Allergy AMS strategy Antibiograms Antimicrobial Bloodstream CNS Infections General Practice Guidelines Health Pathology NSW HNE LHD Hospital practice Infection prevention Infectious diseases Journal paper Microbiology Myths & Misconceptions News Patient information Respiratory Salutary tale SexuallyTxDis Skin/soft tissue Uncategorized Urinary tract infections Weird facts
Top Posts & Pages
- Is it really cellulitis? - differential diagnosis of a red leg
- Why do Gram positive and Gram negative bacteria show different antibiotic susceptibility patterns?
- Q10 - Remembering antibiotics and their classes
- Alternative recommended antibiotics to ceftriaxone by syndrome and bug
- Is that second course of antibiotics really necessary?
- What are cumulative antibiograms ?
- Oral antibiotics for paronychia: unexpected outcomes of 'killing a fly with a cannon'
- Trap - cellulitis or an acute Charcot's foot ?
- Why does our local CAP guideline differ from Australian Therapeutic Guidelines?
- PRINTING POSTINGS FROM AIMED
Join 550 other subscribers